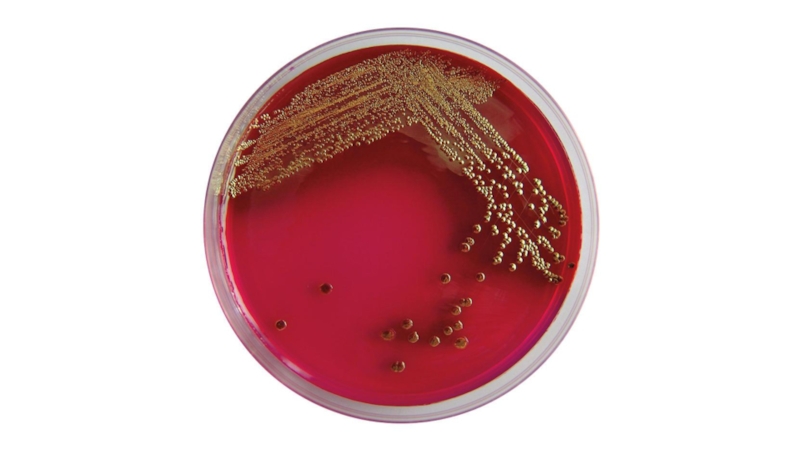
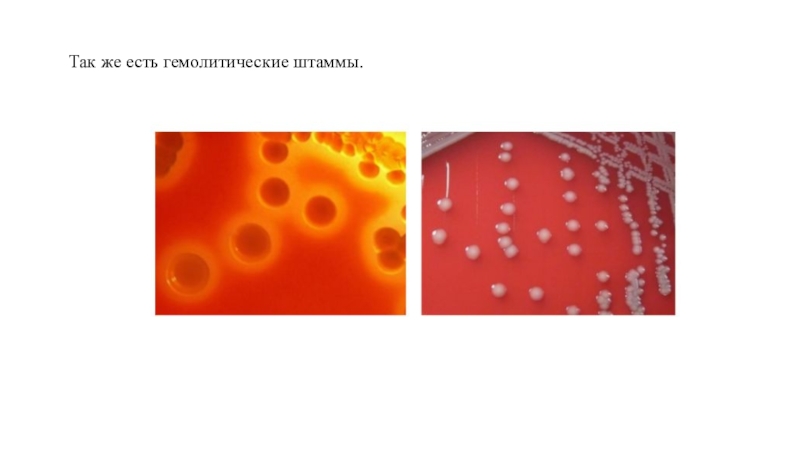

Разделы презентаций
- Разное
- Английский язык
- Астрономия
- Алгебра
- Биология
- География
- Геометрия
- Детские презентации
- Информатика
- История
- Литература
- Математика
- Медицина
- Менеджмент
- Музыка
- МХК
- Немецкий язык
- ОБЖ
- Обществознание
- Окружающий мир
- Педагогика
- Русский язык
- Технология
- Физика
- Философия
- Химия
- Шаблоны, картинки для презентаций
- Экология
- Экономика
- Юриспруденция
Эшерихии
Содержание
- 1. Эшерихии
- 2. E. coli
- 3. Морфология.Гр-Подвижные (перитрихии), но некоторые могут быть неподвижныМногие штаммы образуют капсулуСпор не образуют
- 4. Культуральные свойства.являются аэробами или факультативными анаэробамихорошо растут
- 5. Слайд 5
- 6. Так же есть гемолитические штаммы.
- 7. Биохимическая активность.Эшерихии обладают высокой биохимической активностью –
- 8. АГ структураО - АГН - АГК -
- 9. Слайд 9
- 10. Факторы патогенности.1) Эндотоксин (ЛПС). 2) Термолабильные (LT
- 11. Патогенез.
- 12. Слайд 12
- 13. Клиническая картина.Многообразна. Зависит от локализации инфекции и действующих факторов патогенности
- 14. Диагностика Исследуемый материал при кишечных эшерихиозах –
- 15. Лечение.1) Востановление водно - солевого баланса2) Бактериофаг3)
- 16. Слайд 16
- 17. Скачать презентанцию
Слайды и текст этой презентации
Слайд 3Морфология.
Гр-
Подвижные (перитрихии), но некоторые могут быть неподвижны
Многие штаммы образуют капсулу
Спор
не образуют
Слайд 4Культуральные свойства.
являются аэробами или факультативными анаэробами
хорошо растут на простых питательных
средах
Рост на ППС: эшерихии образуют колонии средних размеров, серо-белые, гладкие,
влажные, блестящие, с ровными краями (S-форма)Рост на ЖПС: равномерное помутнение, иногда образуют незначительный осадок
Эндо - Л+
Плоскирева - брусничного цвета
Левина - темно - фиолетовые
Слайд 7Биохимическая активность.
Эшерихии обладают высокой биохимической активностью – ферментируют с образованием
кислоты и газа глюкозу, лактозу, мальтозу, арабинозу, галактозу, маннит. Дульцит
и сахарозу большинство штаммов кишечной палочки не ферментирует.Протеолитическая активность у эшерихий выражена слабо - желатин они не разжижают, образуют индол, не образуют сероводорода.
Слайд 8АГ структура
О - АГ
Н - АГ
К - АГ (А -
термостабильный; B,L - термолабильный)
F - АГ (пилли)
Количество возможных комбинаций О-,
К- и Н-антигенов превышает 2000. Антигенная структура эшерихий представляет собой формулу, в которой указываются буквенные и цифровые обозначения антигенов, разделенные двоеточием, например, О101:К5:Н10.Слайд 10Факторы патогенности.
1) Эндотоксин (ЛПС).
2) Термолабильные (LT - 1 и
2) и термостабильные (ST - 1 и 2) энтеротоксины .
3)
Цитотоксин SLT (Шига - подобные).4) CNF (цитотоксический некротический фактор) типа 1 и 2 (CNF 1/2)
5) CLDT (cytolethal distending toxin - цитолетальный дилатирующий или разрыхляющий токсин) обусловливает фрагментацию ядра, увеличение и гибель клетки. (Кодируется геном cdt).
6) Адгезины СFА/I-СFА/V1 (англ. colonization factor antigen) представляют собой фимбриальные структуры (кодируются плазмидой)
7) Адгезин Adhesion Henle-407 также относятся к фимбриальным факторам, выявляемым по способности бактерий прикрепляться к клеткам Henle-407
8) Белок наружной мембраны ЕАF или интимин относится к числу афимбриальных адгезинов. (кодируется хромосомным геном еаеА)
9) Афимбриальные адгезины, кодируемые хромосомным геном afa, обусловливают адгезию эшерихий на рецепторах уроэпителиальных клеток
10) Интимин - белок кодируется геном eae. Комплекс интимина с рецептором Tir инициирует полимеризацию актина цитоскелета в области прикрепления бактерий. В результате этого облегчается процесс проникновения бактерий в эпителиальные клетки..
11) Система секреции III типа (Т3SS) обеспечивает перенос эффекторных бактериальных белков из микробной клетки непосредственно в цитоплазму эукариотической клетки
12) Гемолизин (hly нуклеоид или плазмида)
13) Колицины.
Слайд 13Клиническая картина.
Многообразна. Зависит от локализации инфекции и действующих факторов патогенности
Слайд 14Диагностика
Исследуемый материал при кишечных эшерихиозах – фекалии, рвотные массы,
пищевые продукты. При парентеральных эшерихиозах исследуют материал из соответствующего очага
(моча, кровь). Первичный посев проводят на среду Эндо.Лактозопозитивные колонии исползуют в РА на стекле с диагностическими поливалентными эшерихиозными сыворотками, а также пересевают на комбинированную среду и скошенный агар для последующей биохимической и серологической идентификации.
+антибиотикограмма
Слайд 15Лечение.
1) Востановление водно - солевого баланса
2) Бактериофаг
3) Эритромицин и последующая
корректировка лечения в зависимости от результатов антибиотикограммы.
4) Препараты для нормализации
микрофлоры (про-,пре-, мета- и другие биотики)Профилактика.
Специфическа:
Специфическая профилактика эшерихиозов не разработана
Неспецифическая:
- соблюдение санитарно-гигиенических правил
- правильная термическая обработка пищевых продуктов
- соблюдению правил личной гигиены и других мероприятий аналогичных таковым при кишечных инфекциях.